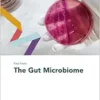
Fast Facts: The Gut Microbiome (EPUB)

Fast Facts: Thalassemia Syndromes – Arabic (PDF)
5 $
Format: Publisher PDF
File Size : 17.9 MB
Category: Clinical Medicine
By unknown author
Product Details
Language : Arabic
ISBN-10 : 3318072532
ISBN-13 : 978-3318072532
Be the first to review “Fast Facts: Thalassemia Syndromes – Arabic (PDF)” Cancel reply
You must be logged in to post a review.

Reviews
There are no reviews yet.